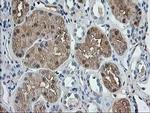
Aminoacylase Antibody in Immunohistochemistry (Paraffin) (IHC (P))

Search
Invitrogen
Aminoacylase Monoclonal Antibody (OTI1D4)
{{$productOrderCtrl.translations['antibody.pdp.commerceCard.promotion.promotions']}}
{{$productOrderCtrl.translations['antibody.pdp.commerceCard.promotion.viewpromo']}}
{{$productOrderCtrl.translations['antibody.pdp.commerceCard.promotion.promocode']}}: {{promo.promoCode}} {{promo.promoTitle}} {{promo.promoDescription}}. {{$productOrderCtrl.translations['antibody.pdp.commerceCard.promotion.learnmore']}}
图: 1 / 7
Aminoacylase Antibody (MA5-25617) in IHC (P)

Please note: We are reviewing Western blot images included in the antibody testing data in our catalog, including those provided by third parties. Unless expressly labeled or annotated as “raw-unedited”, Western blot images included in the antibody testing data in our catalog may have been edited, optimized or otherwise adjusted for presentation.
产品信息
MA5-25617
种属反应
宿主/亚型
分类
类型
克隆号
抗原
偶联物
形式
浓度
规格
纯化类型
保存液
内含物
保存条件
运输条件
RRID
靶标信息
ACY1 encodes a cytosolic, homodimeric, zinc-binding enzyme that catalyzes the hydrolysis of acylated L-amino acids to L-amino acids and an acyl group, and has been postulated to function in the catabolism and salvage of acylated amino acids. This gene is located on chromosome 3p21. 1, a region reduced to homozygosity in small-cell lung cancer (SCLC), and its expression has been reported to be reduced or undetectable in SCLC cell lines and tumors. The amino acid sequence of human aminoacylase-1 is highly homologous to the porcine counterpart, and this enzyme is the first member of a new family of zinc-binding enzymes. Mutations in this gene cause aminoacylase-1 deficiency, a metabolic disorder characterized by central nervous system defects and increased urinary excretion of N-acetylated amino acids. Alternative splicing of this gene results in multiple transcript variants. Read-through transcription also exists between this gene and the upstream ABHD14A (abhydrolase domain containing 14A) gene. A related pseudogene has been identified on chromosome 18.
仅用于科研。不用于诊断过程。未经明确授权不得转售。
篇参考文献 (0)
生物信息学
蛋白别名: ACY-1; Aminoacylase-1; N-acyl-L-amino-acid amidohydrolase
基因别名: 1110014J22Rik; Acy-1; ACY1
UniProt ID: (Mouse) Q99JW2
Entrez Gene ID: (Mouse) 109652




